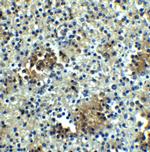
ABCA7 Antibody in Immunohistochemistry (IHC)

Search
Invitrogen
ABCA7 Polyclonal Antibody
{{$productOrderCtrl.translations['antibody.pdp.commerceCard.promotion.promotions']}}
{{$productOrderCtrl.translations['antibody.pdp.commerceCard.promotion.viewpromo']}}
{{$productOrderCtrl.translations['antibody.pdp.commerceCard.promotion.promocode']}}: {{promo.promoCode}} {{promo.promoTitle}} {{promo.promoDescription}}. {{$productOrderCtrl.translations['antibody.pdp.commerceCard.promotion.learnmore']}}

Please note: We are reviewing Western blot images included in the antibody testing data in our catalog, including those provided by third parties. Unless expressly labeled or annotated as “raw-unedited”, Western blot images included in the antibody testing data in our catalog may have been edited, optimized or otherwise adjusted for presentation.
产品信息
PA5-34396
种属反应
宿主/亚型
分类
类型
抗原
偶联物
形式
浓度
规格
纯化类型
保存液
内含物
保存条件
运输条件
RRID
产品详细信息
A suggested positive control is 293 cell lysate.
PA5-34396 can be used with blocking peptide PEP-1438.
靶标信息
ATP-binding cassette (ABC) transporters are an evolutionarily conserved family that use ATP hydrolysis to catalyze the transport of various molecules across cell membranes. They are divided into seven distinct subfamilies (ABC1, MDR/TAP, MRP, ALD, OABP, GCN20, White). ABCA7, a member of the ABC1 subfamily, is a full-size ABC transporter consisting of two sets of the multiple membrane-spanning domains plus the Walker motifs for the ATP interaction. ABCA7 shows the highest homology to ABCA1, an essential molecule for cholesterol homeostasis. The high expression levels of ABCA7 in peripheral leukocytes, thymus, spleen and bone marrow suggests a role in the immune system lipid homeostasis.
仅用于科研。不用于诊断过程。未经明确授权不得转售。
篇参考文献 (0)
生物信息学
蛋白别名: ABC 1 antibody; ABC Transporter 1; ABC1; ABC1 antibody; ABCA-SSN; ATP-binding cassette sub-family A member 7; Autoantigen SS-N; CERP; CERP antibody; EC 2.2.1.1; EC 3.6.3; EC 3.6.3.41; FLJ40025; Macrophage ABC transporter; Phospholipid-transporting ATPase ABCA7
基因别名: ABCA7
Entrez Gene ID: (Human) 10347




